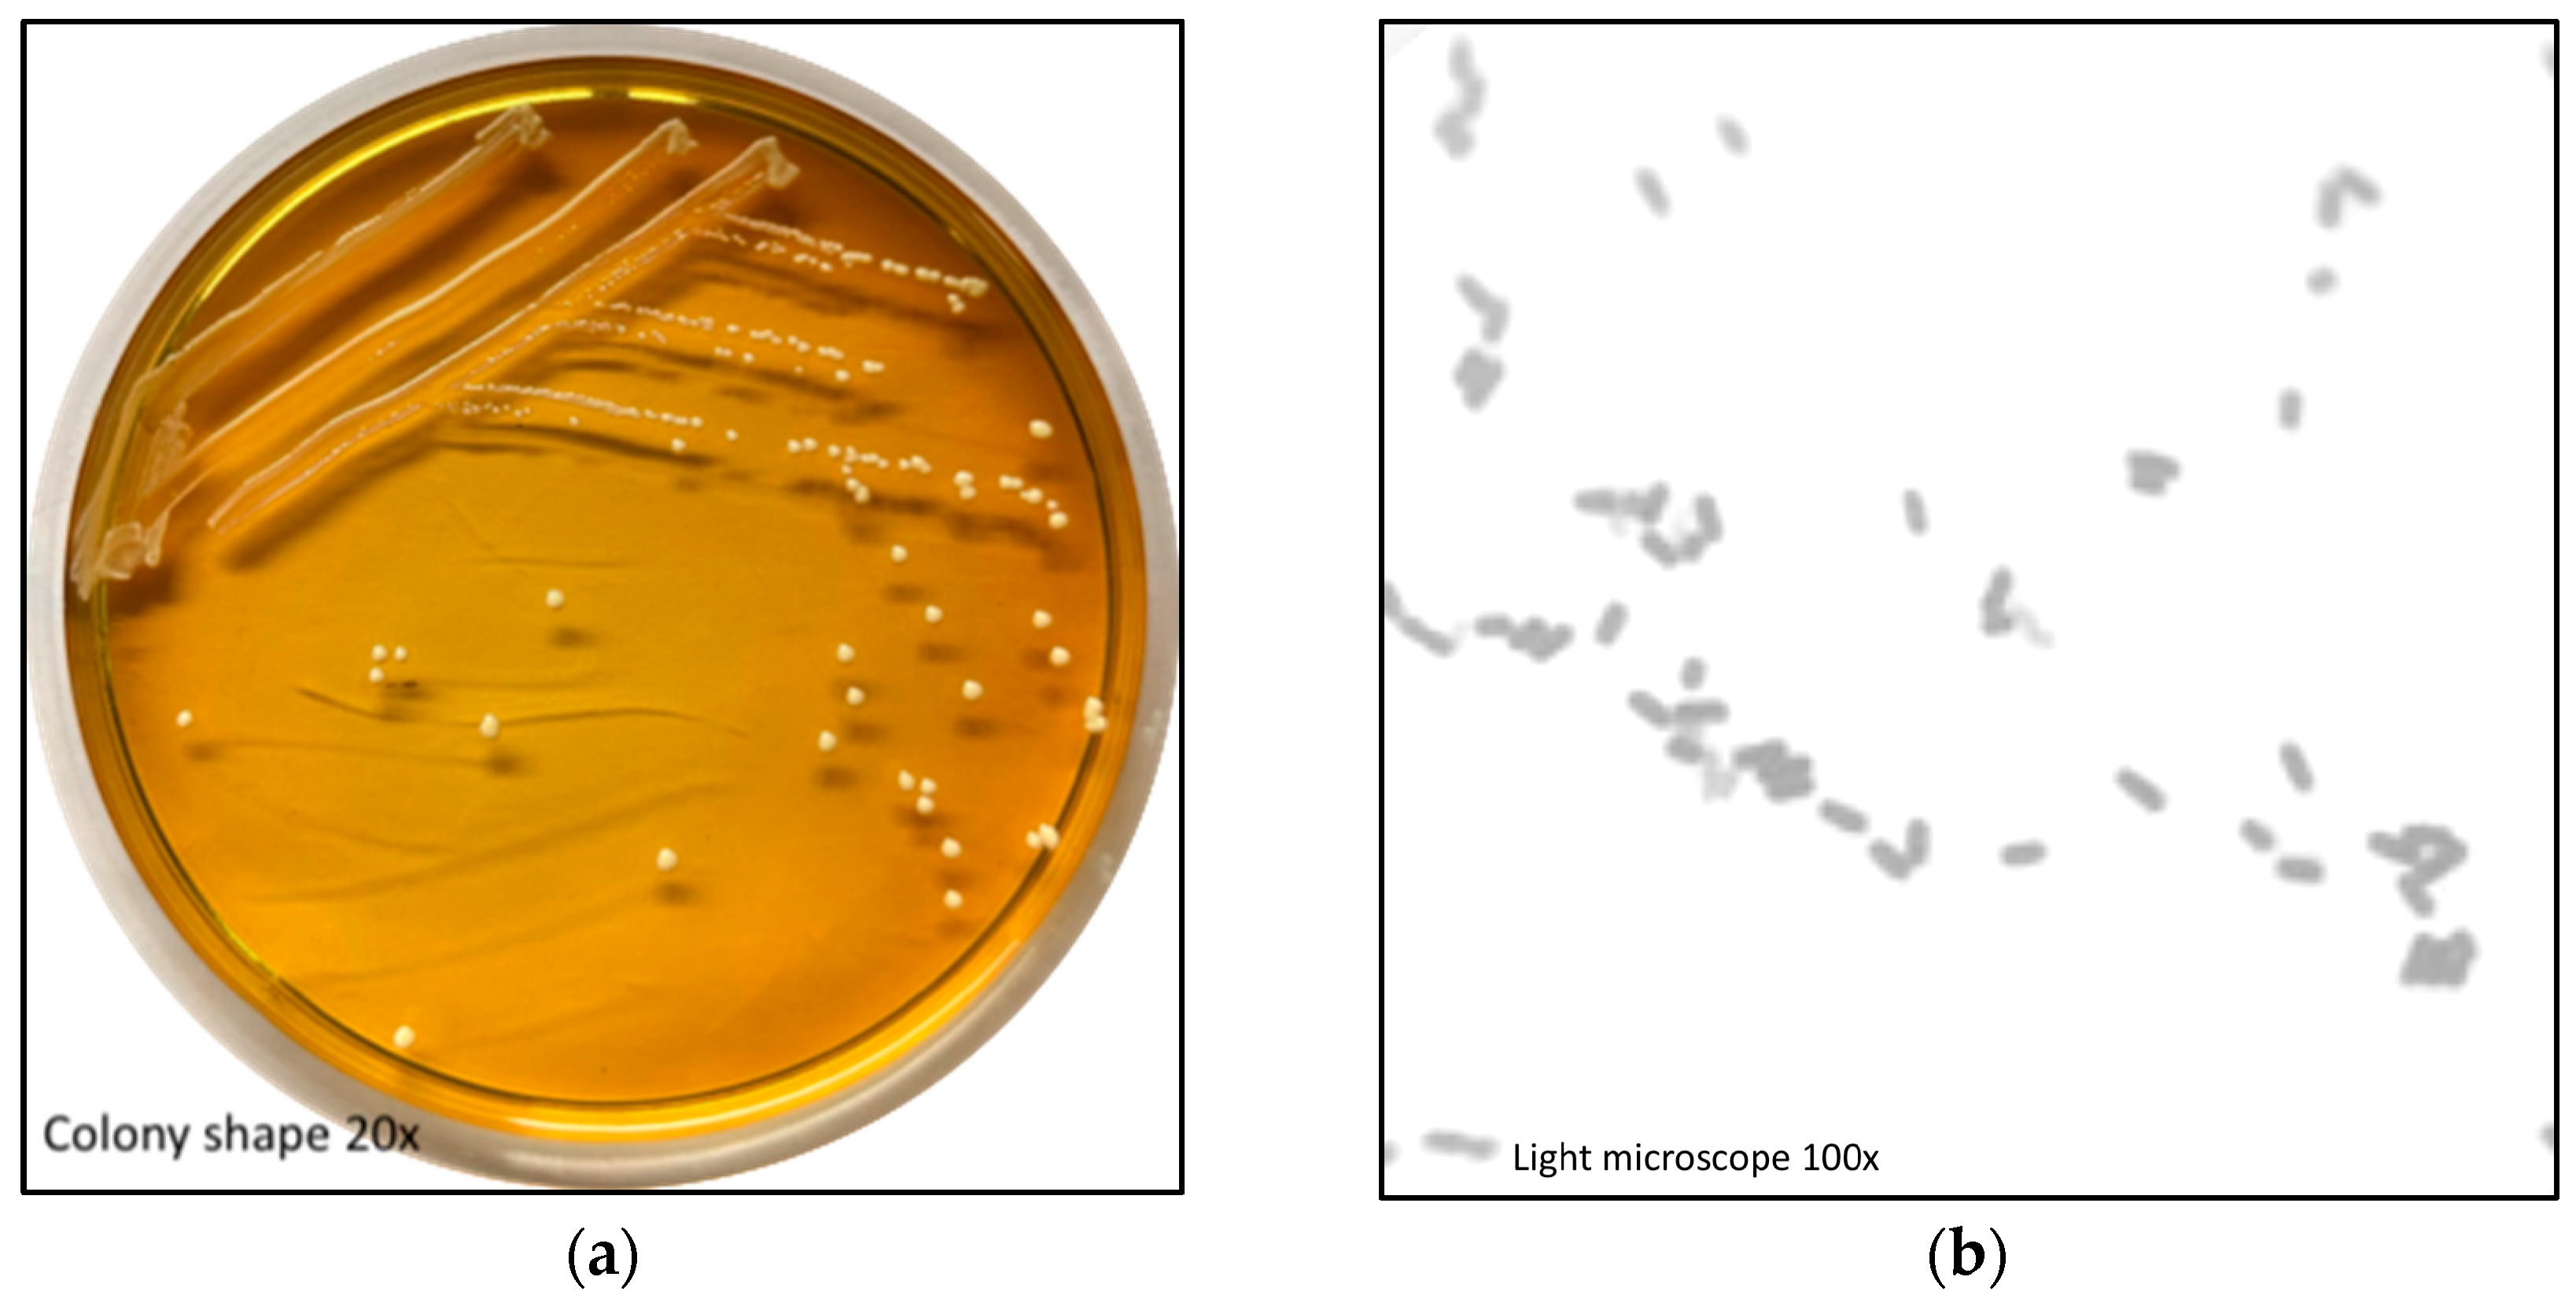
Fermentation 11 00403 g001

In Vitro Preliminary Characterization of Lactiplantibacillus plantarum BG112 for Use as a Starter Culture for Industrial Dry-Fermented Meats
Abstract
1. Introduction
2. Materials and Methods
2.1. Strain
2.2. Cell Morphology and Biochemical Tests
2.3. Carbohydrate Fermentation Profile
2.4. Probiotic Characterization of Pure Culture
2.4.1. Proteolytic Capacity
2.4.2. Auto-Aggregation Test
2.4.3. Tolerance to Simulated Gastric Secretion Conditions
2.4.4. Tolerance to Bile Resistance
2.4.5. Antimicrobial Activity
2.4.6. Evaluation of Growth Kinetics Under Conditions of Fermented Dry-Cured Sausage Processing: Tolerance to Low pH and Resistance to Sodium Chloride and Sodium Nitrite
2.5. Safety Evaluation of Selected Strain
2.5.1. Antibiotic Susceptibility Assay
2.5.2. Hemolytic Activity
2.5.3. DNAse Activity
2.6. Statistical Analysis
3. Results and Discussion
3.1. L. Plantarum BG112
3.2. Carbohydrate Fermentation
3.3. Proteolytic Capacity and Auto-Aggregation Test
3.4. Tolerance to Simulated Gastric Conditions and Bile Salt Resistance
3.5. Antimicrobial Activity
3.6. Tolerance to Low pH, Sodium Chloride Concentrations, and Sodium Nitrite
3.7. Safety Aspects
3.8. Implications for Application in Traditional Meat Products and Comparison with Commercial and Autochthonous Cultures
4. Conclusions
Author Contributions
Funding
Institutional Review Board Statement
Informed Consent Statement
Data Availability Statement
Acknowledgments
Conflicts of Interest
Abbreviations
| AAC | Argentinean Alimentarius Codex |
| C | control group |
| CFUs | colony-forming units |
| DNAse | Deoxyribonuclease |
| FAO | Agriculture Organization of the United Nations |
| GS | gastric solution |
| IST | Iso-Sensitest |
| LAB | lactic acid bacteria |
| MICs | minimum inhibitory concentrations |
| MS | moderately sensitive |
| PBS | phosphate-saline buffer |
| R | resistant |
| S | susceptible |
| TSA | Trypticase Soy Agar |
| WHO | World Health Organization |
References
- Seddik, H.A.; Bendali, F.; Gancel, F.; Fliss, I.; Spano, G.; Drider, D. Lactobacillus plantarum and Its Probiotic and Food Potentialities. Probiotics Antimicrob. Proteins 2017, 9, 111–122. [Google Scholar] [CrossRef] [PubMed]
- Hill, C.; Guarner, F.; Reid, G.; Gibson, G.R.; Merenstein, D.J.; Pot, B.; Morelli, L.; Canani, R.B.; Flint, H.J.; Salminen, S.; et al. Expert consensus document: The International Scientific Association for Probiotics and Prebiotics consensus statement on the scope and appropriate use of the term probiotic. Nat. Rev. Gastroenterol. Hepatol. 2014, 11, 506–514. [Google Scholar] [CrossRef]
- Bağdatli, A.; Kundakci, A. Optimization of compositional and structural properties in probiotic sausage production. J. Food Sci. Technol. 2016, 53, 1679–1689. [Google Scholar] [CrossRef]
- Talon, R.; Leroy, S. Fermented Foods: Fermented Meat Products and the Role of Starter Cultures. In Encyclopedia of Food Microbiology, 2nd ed.; Elsevier: Amsterdam, The Netherlands, 2014; Volume 1. [Google Scholar] [CrossRef]
- Kołożyn-Krajewska, D.; Dolatowski, Z.J. Probiotics in fermented meat products. Ferment. Meat Products: Health Aspects; CRC Press: Boca Raton, FL, USA, 2009; pp. 294–318. [Google Scholar] [CrossRef]
- Bertuci, M.L.; Alves Junior, C.A.; Souza, C.V.B.; Penna, A.L.B.; da Silva Barretto, A.C. Bio preservation capacity of potentially probiotic Lacticaseibacillus strains in fermented sausage. Int. J. Food Sci. Technol. 2023, 58, 6253–6262. [Google Scholar] [CrossRef]
- Rubio, R.; Jofré, A.; Aymerich, T.; Guàrdia, M.D.; Garriga, M. Nutritionally enhanced fermented sausages as a vehicle for potential probiotic lactobacilli delivery. Meat Sci. 2014, 96, 937–942. [Google Scholar] [CrossRef]
- De Vuyst, L.; Falony, G.; Leroy, F. Probiotics in fermented sausages. Meat Sci. 2008, 80, 75–78. [Google Scholar] [CrossRef]
- Pasqualin Cavalheiro, C.; Ruiz-Capillas, C.; Herrero, A.M.; Jiménez-Colmenero, F.; Ragagnin de Menezes, C.; Martins Fries, L.L. Application of probiotic delivery systems in meat products. Trends Food Sci. Technol. 2015, 46, 120–131. [Google Scholar] [CrossRef]
- Fenster, K.; Freeburg, B.; Hollard, C.; Wong, C.; Laursen, R.R.; Ouwehand, A.C. The production and delivery of probiotics: A review of a practical approach. Microorganisms 2019, 7, 83. [Google Scholar] [CrossRef]
- Bis-Souza, C.V.; Penna, A.L.B.; da Silva Barretto, A.C. Applicability of potentially probiotic Lactobacillus casei in low-fat Italian type salami with added fructooligosaccharides: In vitro screening and technological evaluation. Meat Sci. 2020, 168, 108186. [Google Scholar] [CrossRef]
- Sirini, N.; Munekata, P.E.S.; Lorenzo, J.M.; Stegmayer, M.Á.; Pateiro, M.; Pérez-álvarez, J.Á.; Sepúlveda, N.; Sosa-Morales, M.E.; Teixeira, A.; Fernández-López, J.; et al. Development of Healthier and Functional Dry Fermented Sausages: Present and Future. Foods 2022, 11, 1128. [Google Scholar] [CrossRef]
- Yang, Y.; Zhao, C.; Diao, M.; Zhong, S.; Sun, M.; Sun, B.; Ye, H.; Zhang, T. The Prebiotic Activity of Simulated Gastric and Intestinal Digesta of Polysaccharides from the Hericium erinaceus. Molecules 2018, 23, 3158. [Google Scholar] [CrossRef]
- Moraes Filho, M.L.; Busanello, M.; Garcia, S. Probiotic creamy soy sauce with Lactobacillus plantarum BG 112. Br. Food J. 2019, 121, 2746–2758. [Google Scholar] [CrossRef]
- Machado Vasconcelos, L.I.; da Silva-Buzanello, R.A.; Kalschne, D.L.; Scremin, F.R.; Stival Bittencourt, P.R.; Gaudêncio Dias, J.T.; Canan, C.; Corso, M.P. Functional fermented sausages incorporated with microencapsulated Lactobacillus plantarum BG 112 in Acrycoat S100. LWT 2021, 148, 111596. [Google Scholar] [CrossRef]
- Rojas-Rejón, Ó.A.; Gonzalez-Figueredo, C.; Quintero-Covarrubias, A.R.; Salda-Jáuregui, A. Growth of Lactiplantibacillus plantarum BG112 in Batch and Continuous Culture with Camellia sinensis as Prebiotic. Fermentation 2024, 10, 487. [Google Scholar] [CrossRef]
- FAO/WHO Working Group. Report on Drafting Guidelines for the Evaluation of Probiotics in Food; FAO/WHO Working Group: London, ON, Canada, 2002; pp. 1–11. [Google Scholar]
- Olajuyigbe, F.M.; Ajele, J.O.; Ajele, J.O. Production Dynamics of Extracellular Protease from Bacillus Species. Artic. Afr. J. Biotechnol. 2005, 4, 776–779. [Google Scholar]
- Del Re, B.; Sgorbati, B.; Miglioli, M.; Palenzona, D. Adhesion, autoaggregation and hydrophobicity of 13 strains of Bifidobacterium longum. Lett. Appl. Microbiol. 2000, 31, 438–442. [Google Scholar] [CrossRef]
- Villareal, F. Aislamiento y Caracterización de Lactobacilos intestinales con Potencial Probiótico. Ph.D. Thesis, Universidad Nacional del Litoral, Santa Fe, Argentina, 2002. Available online: https://bibliotecavirtual.unl.edu.ar:8443/bitstream/handle/11185/399/tesis.pdf?sequence=3&isAllowed=y (accessed on 22 February 2025).
- Colello, R.; Ruiz, M.J.; Padín, V.M.; Rogé, A.D.; Leotta, G.; Padola, N.L.; Etcheverría, A.I. Detection and characterization of Salmonella serotypes in the production chain of two pig farms in Buenos Aires Province, Argentina. Front. Microbiol. 2018, 9, 1370. [Google Scholar] [CrossRef]
- Colello, R. Detección y Caracterización Molecular de Bacterias Implicadas en Enfermedades Transmitidas por Alimentos en la Cadena Productiva Porcina. Ph.D. Thesis, Universidad Nacional del Centro de la Provincia de Buenos Aires, Tandil, Argentina, 2018. Available online: https://ridaa.unicen.edu.ar:8443/server/api/core/bitstreams/ac12bee7-d701-4490-b8b9-e577de41cddf/content (accessed on 9 January 2025).
- Ruiz, M.J.; Colello, R.; Padola, N.L.; Etcheverría, A.I. Inhibitory capacity of Lactobacillus spp. against pathogens involved in foodborne diseases. Rev. Argent. De. Microbiol. 2017, 49, 174–177. [Google Scholar] [CrossRef]
- Argentinean Alimentarius Codex. 2017, pp. 15–1105. Available online: https://www.argentina.gob.ar/sites/default/files/anmat-cap-18-aditivos.pdf (accessed on 9 January 2025).
- Klare, I.; Konstabel, C.; Müller-Bertling, S.; Reissbrodt, R.; Huys, G.; Vancanneyt, M.; Swings, J.; Goossens, H.; Witte, W. Evaluation of new broth media for microdilution antibiotic susceptibility testing of lactobacilli, pediococci, lactococci, and bifidobacteria. Appl. Environ. Microbiol. 2005, 71, 8982–8986. [Google Scholar] [CrossRef]
- Food European & Authority Safety. Guidance on the assessment of bacterial susceptibility to antimicrobials of human and veterinary importance. EFSA J. 2012, 10, 2740. [Google Scholar] [CrossRef]
- Iraporda, C.; Rubel, A.I.; Manrique, G.D.; Abraham, A.G. Lactic acid bacteria strains isolated from Jerusalem artichoke (Helianthus tuberosus L.) tubers as potential probiotic candidates. Res. Sq. 2025. preprint. [Google Scholar] [CrossRef]
- Shuhadha, M.F.F.; Panagoda, G.J.; Madhujith, T.; Jayawardana, N.W.I.A. Evaluation of probiotic attributes of Lactobacillus sp. isolated from cow and buffalo curd samples collected from Kandy. Ceylon Med. J. 2017, 62, 159. [Google Scholar] [CrossRef]
- González, J.; Hernandez, L.B.; Tabera, A.; Bustamante, A.V.; Sanso, A.M. Methicillin-Resistant Staphylococcus aureus and Coagulase-Negative Staphylococcus from School Dining Rooms in Argentina. Foodborne Pathog. Dis. 2023, 21, 44–51. [Google Scholar] [CrossRef]
- Jia, F.F.; Zhang, L.J.; Pang, X.H.; Gu, X.X.; Abdelazez, A.; Liang, Y.; Sun, S.S.; Meng, X.C. Complete genome sequence of bacteriocin-producing Lactobacillus plantarum KLDS1.0391, a probiotic strain with gastrointestinal tract resistance and adhesion to the intestinal epithelial cells. Genomics 2017, 109, 432–437. [Google Scholar] [CrossRef]
- Akhavan, N.; Hrynkiewicz, K.; Thiem, D.; Randazzo, C.; Walsh, A.M.; Guinan, K.J.; O’Sullivan, J.T.; Stadnicka, K. Evaluation of probiotic growth stimulation using prebiotic ingredients to optimize compounds for in ovo delivery. Front. Microbiol. 2023, 14, 1242027. [Google Scholar] [CrossRef]
- Cunningham, M.; Azcarate-Peril, M.A.; Barnard, A.; Benoit, V.; Grimaldi, R.; Guyonnet, D.; Holscher, H.D.; Hunter, K.; Manurung, S.; Obis, D.; et al. Shaping the Future of Probiotics and Prebiotics. Trends Microbiol. 2021, 29, 667–685. [Google Scholar] [CrossRef]
- Anekella, K.; Pérez-Díaz, I.M. Characterization of robust Lactobacillus plantarum and Lactobacillus pentosus starter cultures for environmentally friendly low-salt cucumber fermentations. J. Food Sci. 2020, 85, 3487–3497. [Google Scholar] [CrossRef]
- Ruiz, M.J.; Medina, L.M.; Palacio, M.I.; Vega, M.F.; Etcheverría, S.; Frizzo, L.S.; Etcheverría, A.I. Investigation of some probiotic and technological properties of lactic acid bacteria strains isolated from artisanal sheep milk cheese and their growth in goat milk. Small Rumin. Res. 2024, 238, 107329. [Google Scholar] [CrossRef]
- Janković, T.; Frece, J.; Abram, M.; Gobin, I. Aggregation ability of potential probiotic Lactobacillus plantarum strains. Int. J. Sanit. Eng. Res. 2012, 6, 19–24. [Google Scholar]
- Zago, M.; Fornasari, M.E.; Carminati, D.; Burns, P.; Suàrez, V.; Vinderola, G.; Reinheimer, J.; Giraffa, G. Characterization and probiotic potential of Lactobacillus plantarum strains isolated from cheeses. Food Microbiol. 2011, 28, 1033–1040. [Google Scholar] [CrossRef]
- Bao, Y.; Zhang, Y.; Zhang, Y.; Liu, Y.; Wang, S.; Dong, X.; Wang, Y.; Zhang, H. Screening of potential probiotic properties of Lactobacillus fermentum isolated from traditional dairy products. Food Control 2010, 21, 695–701. [Google Scholar] [CrossRef]
- Anandharaj, M.; Sivasankari, B.; Santhanakaruppu, R.; Manimaran, M.; Rani, R.P.; Sivakumar, S. Determining the probiotic potential of cholesterol-reducing Lactobacillus and Weissella strains isolated from gherkins (fermented cucumber) and south Indian fermented koozh. Res. Microbiol. 2015, 166, 428–439. [Google Scholar] [CrossRef]
- Khalil, E.S.; Manap, M.Y.; Mustafa, S.; Amid, M.; Alhelli, A.M.; Aljoubori, A. Probiotic characteristics of exopolysaccharides-producing Lactobacillus isolated from some traditional Malaysian fermented foods. CyTA—J. Food 2018, 16, 287–298. [Google Scholar] [CrossRef]
- Ruiz, M.J.; Zbrun, M.V.; Signorini, M.L.; Zimmermann, J.A.; Soto, L.P.; Rosmini, M.R.; Frizzo, L.S. In vitro screening and in vivo colonization pilot model of Lactobacillus plantarum LP5 and Campylobacter coli DSPV 458 in mice. Arch Microbiol 2021, 203, 4161–4171. [Google Scholar] [CrossRef]
- Sahu, M. Antibacterial activity of Lactobacillus species against some pathogenic and food spoilage bacteria. Food Biol. 2025, 14, 1–5. [Google Scholar] [CrossRef]
- da Silva Sabo, S.; Vitolo, M.; González, J.M.D.; de Souza Oliveira, R.P. Overview of Lactobacillus plantarum as a promising bacteriocin producer among lactic acid bacteria. Food Res. Int. 2014, 64, 527–536. [Google Scholar] [CrossRef]
- Ibrahim, S.A.; Ayivi, R.D.; Zimmerman, T.; Siddiqui, S.A.; Altemimi, A.B.; Fidan, H.; Esatbeyoglu, T.; Bakhshayesh, R.V. Lactic acid bacteria as antimicrobial agents: Food safety and microbial food spoilage prevention. Foods 2021, 10, 3131. [Google Scholar] [CrossRef]
- Abdel-motaal, H.; Abdelazez, A.; Wang, P.; Abady, G.; Abozaed, S.; Ye, B.; Xu, L.; Zhao, Y.; Niu, J.; Alshehry, G.; et al. Exploring Phenotype, Genotype, and the Production of Promising GABA Postbiotics by Lactiplantibacillus plantarum: A Comprehensive Investigation. Fermentation 2024, 10, 309. [Google Scholar] [CrossRef]
- Ruiz-Moyano, S.; Martín, A.; Benito, M.J.; Nevado, F.P.; Córdoba, M.G. Screening of autochthonous lactic acid bacteria strains from Iberian dry-fermented sausages for potential probiotic use. Meat Sci. 2011, 89, 509–517. [Google Scholar] [CrossRef]

| Carbohydrate | L. plantarum BG112 | |||
|---|---|---|---|---|
| 24 h | 48 h | 72 h | ||
| 1 | CONTROL | − | − | − |
| 2 | GLYcerol | − | − | − |
| 3 | ERYthrol | − | − | − |
| 4 | D-ARAbinose | − | − | − |
| 5 | L-ARAbinose | − | − | − |
| 6 | RIBose | d | + | + |
| 7 | D-XYLose | − | d | d |
| 8 | L-XILose | − | − | − |
| 9 | ADOnitol | − | − | − |
| 10 | β-Methyl-D-Xyloside | − | − | − |
| 11 | GALactose | d | + | + |
| 12 | GLUcose | + | + | + |
| 13 | FRUctose | + | + | + |
| 14 | MaNnosE | + | + | + |
| 15 | SorBosE | − | − | − |
| 16 | RHAmnose | d | d | d |
| 17 | DULcitol | − | − | − |
| 18 | INOsitol | − | − | − |
| 19 | MANnitol | + | + | + |
| 20 | SORbitol | + | + | + |
| 21 | 1-Methyl-D-Mannoside | − | d | + |
| 22 | 1-Methyl-D-Glucoside | − | − | − |
| 23 | N-Acetyl-Glucosamine | d | + | + |
| 24 | AMYgdaline | d | + | + |
| 25 | ARButin | d | + | + |
| 26 | ESCulin | + | + | + |
| 27 | SALicin | + | + | + |
| 28 | CELlobiose | d | + | + |
| 29 | MALtose | d | + | + |
| 30 | LACtose | d | + | + |
| 31 | MELibiose | + | + | + |
| 32 | SAC sucrose | + | + | + |
| 33 | TREhalose | d | + | + |
| 34 | INUlin | − | − | − |
| 35 | MeLeZitose | + | + | + |
| 36 | RAFfinose | − | − | d |
| 37 | AMD starch | − | − | − |
| 38 | GLYcoGen | − | − | − |
| 39 | XyLiTol | − | − | − |
| 40 | GENtiobiose | d | + | + |
| 41 | D-TURanose | d | + | + |
| 42 | D-LYXose | − | − | − |
| 43 | D-TAGatose | d | + | + |
| 44 | D-FUCose | − | − | − |
| 45 | L-FUCose | − | − | − |
| 46 | D-ARabitoL | − | − | − |
| 47 | L-ARabitoL | − | − | − |
| 48 | GlucoNaTe | − | − | d |
| 49 | 2-Keto-Gluconate | − | − | − |
| 50 | 5-Keto-Gluconate | − | − | − |
| Gastric Treatment (CFU/mL) | |||||||
|---|---|---|---|---|---|---|---|
| 0 h | 1 h | 2 h | 3 h | ||||
| C | GS | C | GS | C | GS | C | GS |
| 9.32 ± 0.35 a | 9.36 ± 0.40 a | 9.08 ± 0.33 a | 8.63 ± 0.25 a | 9.47 ± 0.35 a | 8.71 ± 0.23 b | 9.11 ± 0.34 a | 8.73 ± 0.10 a |
| Bile salts treatment | |||||||
| 0.15% w/v Negative | 0.30% w/v Negative | 0.6% w/v Positive | 1.0% w/v Positive | ||||
| 25 °C | Average ± SD (log10 UFC/mL) | |||||
|---|---|---|---|---|---|---|
| 0 h | 2 h | 4 h | 6 h | 7 h | 24 h | |
| Control | 7.79 ± 0.03 a | 7.90 ± 0.00 b | 8.09 ± 0.00 a | 8.30 ± 0.01 a | 8.39 ± 0.00 a | 9.11 ± 0.00 a |
| Sodium nitrite 1 | 7.82 ± 0.01 a | 7.94 ± 0.01 a | 7.99 ± 0.00 b | 8.21 ± 0.00 b | 8.34 ± 0.00 b | 9.08 ± 0.04 ab |
| pH 4.0 | 7.80 ± 0.01 a | 7.81 ± 0.01 d | 7.85 ± 0.03 d | 7.89 ± 0.03 f | 7.95 ± 0.01 h | 8.98 ± 0.00 b |
| pH 4.5 | 7.75 ± 0.00 a | 7.73 ± 0.00 e | 7.78 ± 0.01 e | 7.90 ± 0.00 ef | 8.16 ± 0.00 f | 9.07 ± 0.00 ab |
| pH 5.0 | 7.64 ± 0.02 b | 7.74 ± 0.00 e | 7.80 ± 0.01 e | 8.00 ± 0.01 d | 8.30 ± 0.00 d | 9.12 ± 0.00 a |
| pH 5.5 | 7.88 ± 0.00 a | 7.90 ± 0.01 b | 7.92 ± 0.00 c | 8.20 ± 0.00 c | 8.28 ± 0.00 c | 9.06 ± 0.00 ab |
| 2.5%NaCl | 7.78 ± 0.01 a | 7.84 ± 0.01 c | 7.91 ± 0.00 c | 8.00 ± 0.00 d | 8.18 ± 0.00 e | 9.07 ± 0.07 ab |
| 3.0%NaCl | 7.90 ± 0.00 a | 7.90 ± 0.01 b | 7.90 ± 0.00 c | 7.90 ± 0.00 d | 8.05 ± 0.00 g | 9.11 ± 0.00 a |
| 3.5%NaCl | 7.87 ± 0.02 a | 7.85 ± 0.00 c | 7.85 ± 0.00 d | 7.92 ± 0.00 e | 7.98 ± 0.00 h | 9.06 ± 0.00 ab |
| 15 °C | Average ± SD (log10 UFC/mL) | |||||
| 0 h | 2 h | 4 h | 6 h | 7 h | 24 h | |
| Control | 7.88 ± 0.06 a | 7.87 ± 0.01 b | 7.98 ± 0.00 a | 8.12 ± 0.01 a | 8.19 ± 0.00 a | 9.08 ± 0.04 abc |
| Sodium nitrite 1 | 7.71 ± 0.02 a | 7.69 ± 0.02 de | 7.82 ± 0.00 b | 8.11 ± 0.00 b | 8.27 ± 0.00 b | 9.10 ± 0.00 ab |
| pH 4.0 | 7.81 ± 0.01 a | 7.90 ± 0.01 b | 7.83 ± 0.00 b | 7.88 ± 0.01 cd | 7.91 ± 0.01 e | 8.93 ± 0.00 d |
| pH 4.5 | 7.65 ± 0.02 a | 7.72 ± 0.01 d | 7.70 ± 0.01 c | 7.86 ± 0.00 d | 7.96 ± 0.00 c | 9.03 ± 0.00 c |
| pH 5.0 | 7.86 ± 0.00 a | 8.03 ± 0.02 a | 7.80 ± 0.00 a | 8.10 ± 0.00 b | 8.19 ± 0.00 a | 9.12 ± 0.00 a |
| pH 5.5 | 7.63 ± 0.10 a | 7.68 ± 0.00 de | 7.71 ± 0.01 c | 7.89 ± 0.00 c | 7.95 ± 0.01 d | 9.11 ± 0.00 a |
| 2.5%NaCl | 7.84 ± 0.00 a | 7.82 ± 0.01 c | 7.69 ± 0.00 c | 7.82 ± 0.00 e | 8.07 ± 0.01 b | 9.06 0.00 bc |
| 3.0%NaCl | 7.75 ± 0.09 a | 7.65 ± 0.00 ef | 7.60 ± 0.01 d | 7.69 ± 0.01 g | 7.79 ± 0.02 f | 9.06 ± 0.00 c |
| 3.5%NaCl | 7.61 ± 0.12 a | 7.62 ± 0.01 f | 7.63 ± 0.01 d | 7.78 ± 0.01 f | 7.84 ± 0.01 d | 9.02 ± 0.00 c |
| Antibiotic Sensibility | Hemolytic Capacity | DNAse Activity | ||||
|---|---|---|---|---|---|---|
| AMP | STR | GEN | CIP | VAN | ||
| S | S | S | S | S | − | − |
Disclaimer/Publisher’s Note: The statements, opinions and data contained in all publications are solely those of the individual author(s) and contributor(s) and not of MDPI and/or the editor(s). MDPI and/or the editor(s) disclaim responsibility for any injury to people or property resulting from any ideas, methods, instructions or products referred to in the content. |
© 2025 by the authors. Licensee MDPI, Basel, Switzerland. This article is an open access article distributed under the terms and conditions of the Creative Commons Attribution (CC BY) license (https://creativecommons.org/licenses/by/4.0/).
Share and Cite
Palacio, M.I.; Ruiz, M.J.; Vega, M.F.; Etcheverría, A.I. In Vitro Preliminary Characterization of Lactiplantibacillus plantarum BG112 for Use as a Starter Culture for Industrial Dry-Fermented Meats. Fermentation 2025, 11, 403. https://doi.org/10.3390/fermentation11070403
Palacio MI, Ruiz MJ, Vega MF, Etcheverría AI. In Vitro Preliminary Characterization of Lactiplantibacillus plantarum BG112 for Use as a Starter Culture for Industrial Dry-Fermented Meats. Fermentation. 2025; 11(7):403. https://doi.org/10.3390/fermentation11070403
Chicago/Turabian StylePalacio, María Inés, María Julia Ruiz, María Fernanda Vega, and Analía Inés Etcheverría. 2025. "In Vitro Preliminary Characterization of Lactiplantibacillus plantarum BG112 for Use as a Starter Culture for Industrial Dry-Fermented Meats" Fermentation 11, no. 7: 403. https://doi.org/10.3390/fermentation11070403
APA StylePalacio, M. I., Ruiz, M. J., Vega, M. F., & Etcheverría, A. I. (2025). In Vitro Preliminary Characterization of Lactiplantibacillus plantarum BG112 for Use as a Starter Culture for Industrial Dry-Fermented Meats. Fermentation, 11(7), 403. https://doi.org/10.3390/fermentation11070403

